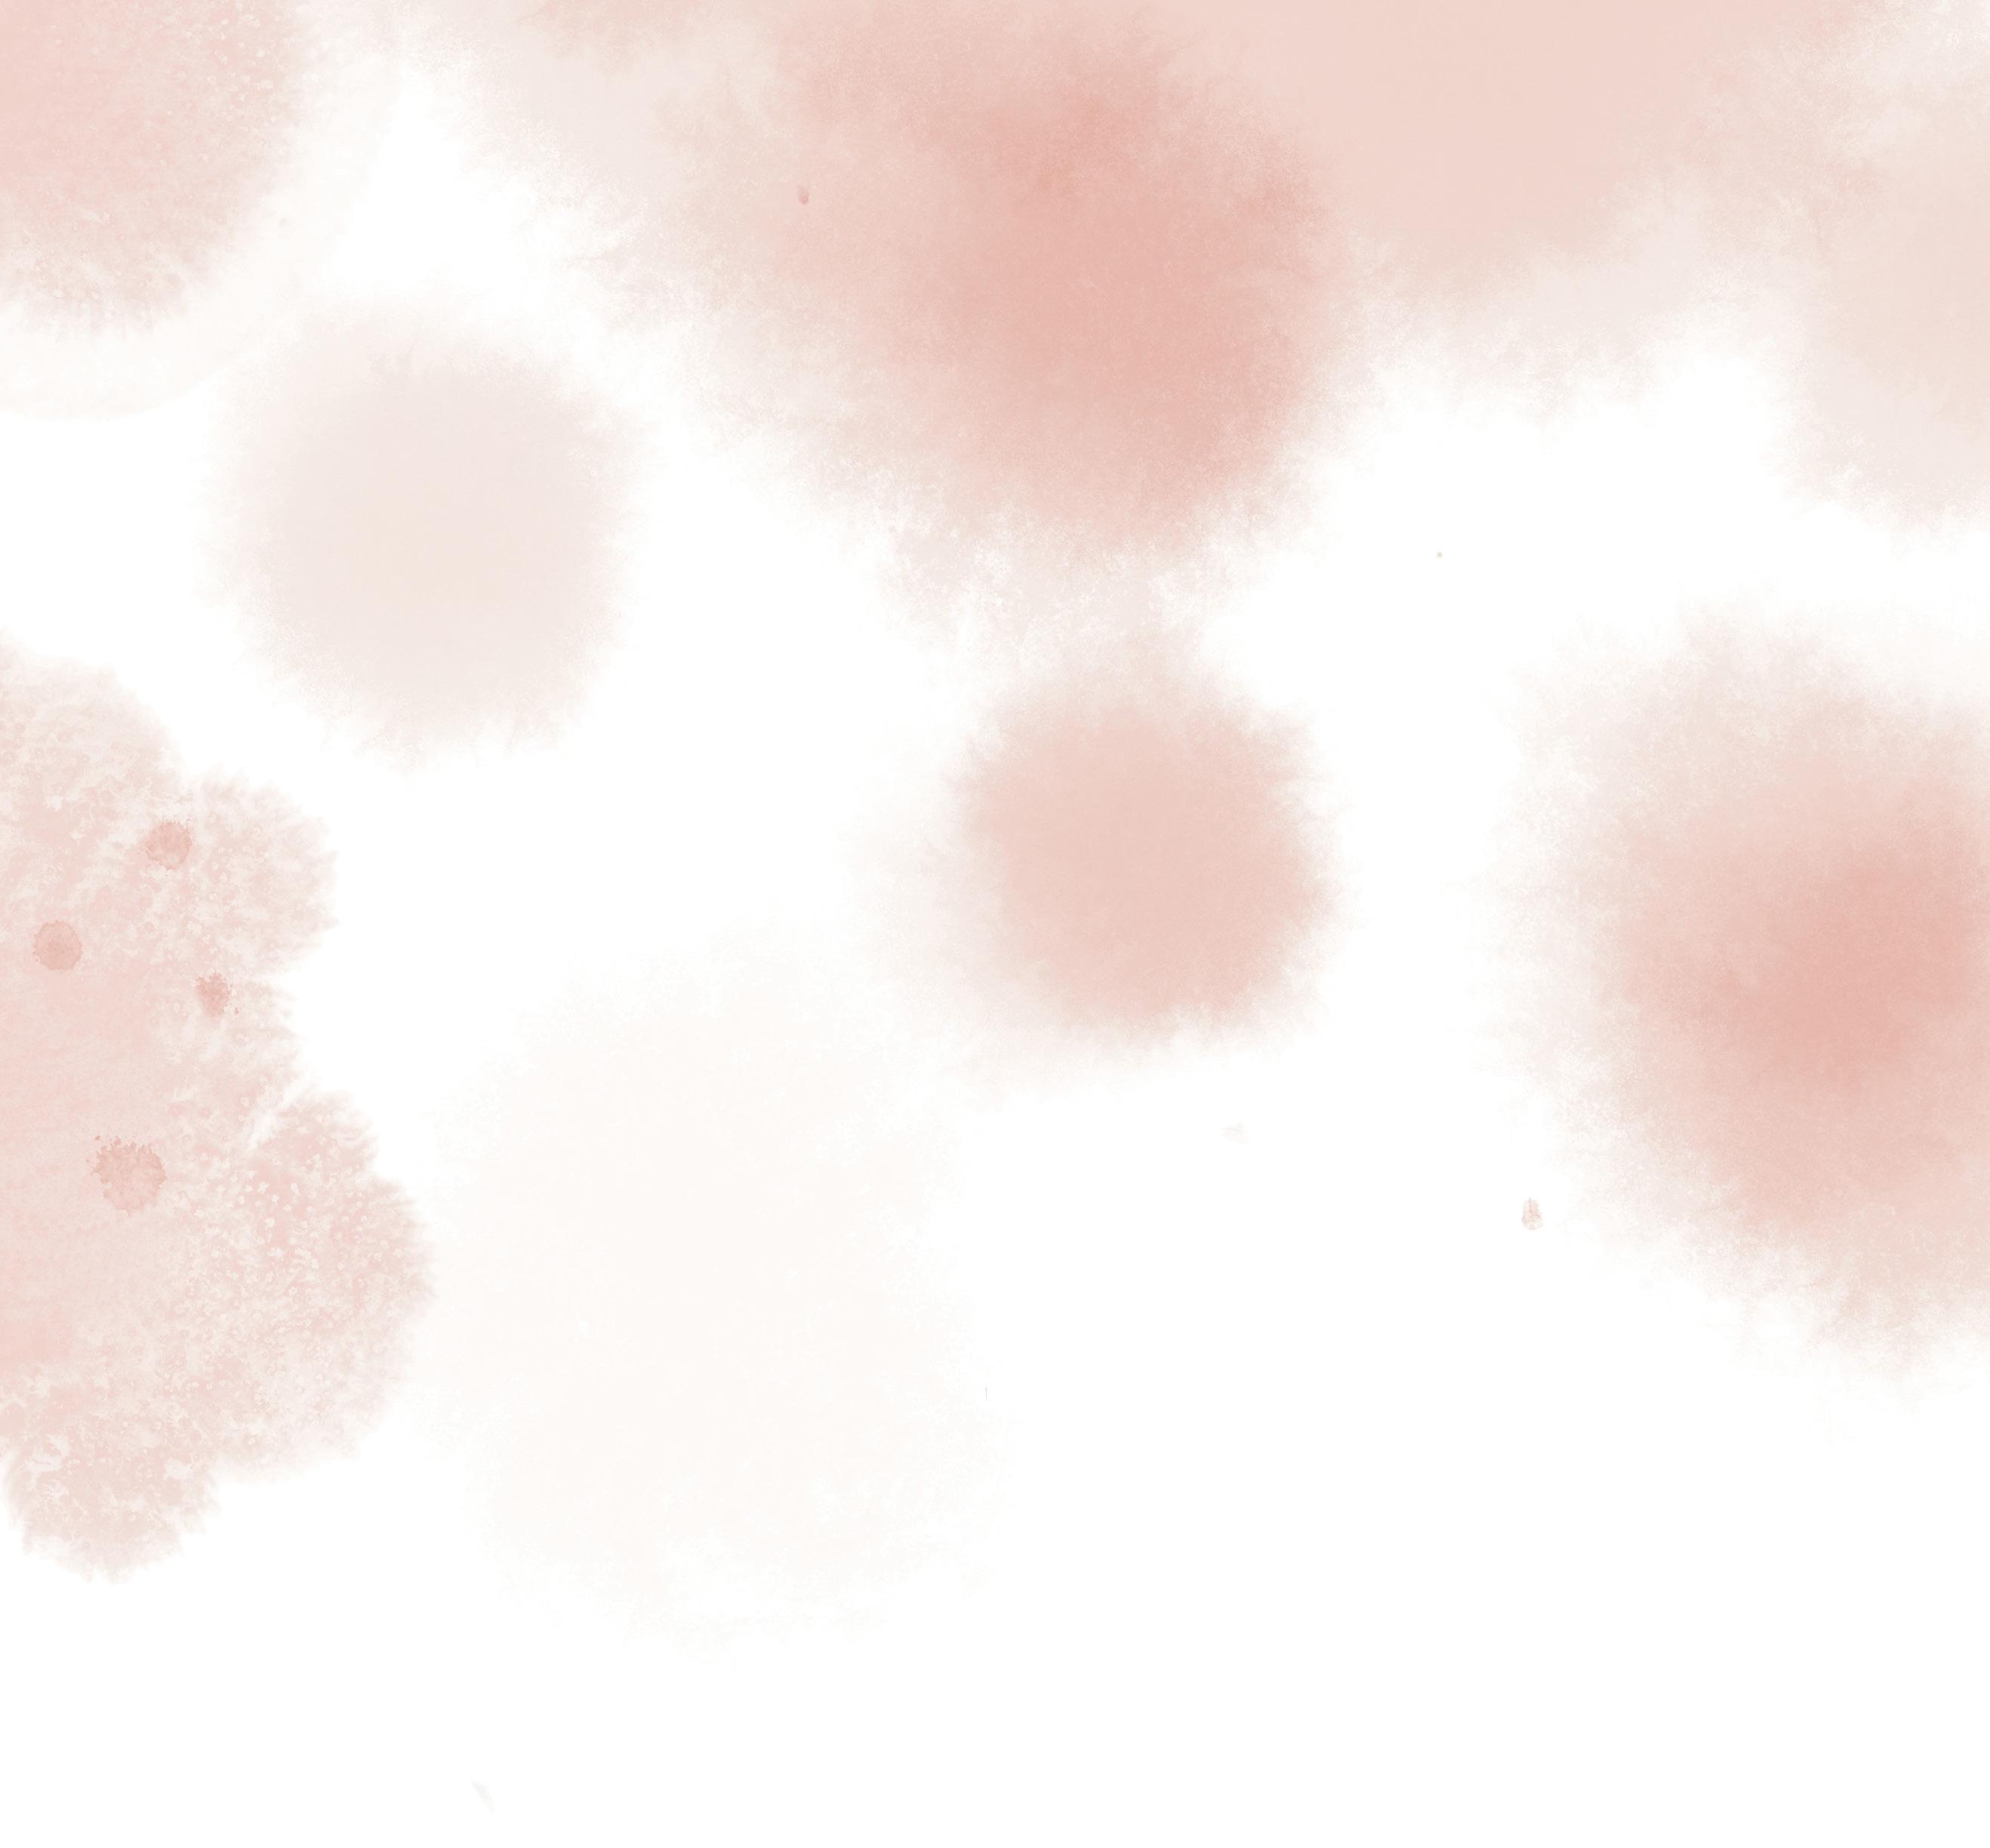

PRENTENBOEKEN VOORJAAR 2023


Wij maken kinderdromen waar
is een vrolijk konijn. Hij is een beetje anders dan de andere konijnen, maar dat is helemaal niet erg. Hij is uniek en blijft helemaal zichzelf!
laat in de avonturen met zijn vriendjes zien dat verschillen gevierd moeten worden. Met een vrolijke lach, een vriendelijk gebaar en een schattig hangend oortje staat hij altijd klaar voor anderen.


Een nieuw avontuur van Rikki!
Dromen van de maan
ISBN 978-9044850826
Een nieuw verhaal over het lieve konijntje Rikki. Voor kleine astronauten en dagdromers vanaf 4 jaar.

Rikki en papa bouwen een raket, maar het is nog een verrassing voor mama. Als hij af is, stellen ze hem trots voor: de RIPA 1. Met het astronautenpak dat mama heeft gemaakt, is Rikki helemaal klaar voor zijn reis naar de maan. Spannend!

Verschijnt: maart 2023 978 90 448 5082 6
Titel: Rikki en de maan
Auteur en illustrator: Guido Van Genechten (Mol) 273 / Geb. 32 pagina’s Formaat: 210 x 290 mm
Promotiemateriaal voor de boekhandel: - raamstickers - consumentenposter
JBC lanceert nieuwe Rikki-pyjama’s
Clavis Uitgeverij
2

Clavis Peuter
Ieder kind houdt van lezen. Ook baby’s en peuters kunnen genieten van warme verhalen en mooie beelden. Maar dan moeten de boeken wel bij hen passen. De titels in onze peuterlijn zijn daarom helemaal op maat gemaakt voor de allerkleinsten: met herkenbare thema’s, rijke taal, leuke personages en stevige pagina’s. Probeer het zelf maar uit: met onze peuterboeken houdt ieder kind van lezen.

Speelse boekjes vol interactie en beweging. Voor kleine beestjes vanaf 12 maanden.
Het leven van de allerkleinsten zit vol eerste keren. Wat doe je op een gewone dag? En wat betekent jarig zijn? Je peuter ontdekt het samen met de vriendjes van Beestenboel!
Feest en leer mee met Beestenboel
Nieuwe delen in de succesreeks!
ISBN 978-9044841848
DAGELIJKS LEVEN
Prijs: € 11,95
Verschijnt: april 2023 isbn 978 90 448 4997 4
Titel: Feest je met me mee? Mijn verjaardag Serie: Beestenboel Auteur en illustrator: Federico Van Lunter (Tongeren) Vanaf 12 maanden / nur 271

Kartonboek 20 pagina’s Formaat: 160 x 160 mm
ISBN 978-9044841848
DAGELIJKS LEVEN
Prijs: € 11,95
Verschijnt: april 2023 isbn 978 90 448 4998 1
Titel: Doe je met me mee? Mijn dagje Serie: Beestenboel Auteur en illustrator: Federico Van Lunter (Tongeren) Vanaf 12 maanden / nur 271 Kartonboek 20 pagina’s Formaat: 160 x 160 mm
5 Clavis Uitgeverij
Vrolijke, leerrijke kartonboekjes waarin het olifantje Billie de wereld rond zich ontdekt. Voor peuters vanaf 12 maanden, met het dagelijks leven van het kind als thema.
Billie is een vrolijk olifantje vol levenslust. Elke dag komt er iets nieuws op zijn pad. Zoals een verjaardagsfeestje of een lekker eetfestijn. Ontdek je met hem mee?
Prijs: € 11,95
Verschijnt: april 2023
isbn 978 90 448 5085 7
Titel: Billie is jarig Serie: Billie

Auteur en illustrator: Mack van Gageldonk (Berkel en Rodenrijs)
Vanaf 12 maanden / nur 271
Kartonboek 24 pagina’s

Formaat: 160 x 160 mm
Prijs: € 11,95
Verschijnt: april 2023 isbn 978 90 448 5086 4
Titel: Billie eet zijn buikje rond Serie: Billie
Auteur en illustrator: Mack van Gageldonk (Berkel en Rodenrijs)
Vanaf 12 maanden / nur 271
Kartonboek 24 pagina’s Formaat: 160 x 160 mm







Prijs: € 11,95 Verschijnt: april 2023 isbn 978 90 448 5084 0 Titel: Mijn dieren Auteur en illustrator: Liesbet Slegers (Herentals) Vanaf 12 maanden / nur 271 Kartonboek 24 pagina’s Formaat: 160 x 160 mm






Beleef en ontdek het verhaal samen Prijs: € 10,95 Verschijnt: februari 2023 isbn 978 90 448 5001 7 Titel: Ruimteraket Serie: Beertje Bo Auteur en illustrator: Benji Davies Oorspronkelijke titel: Bizzy Bear Space Rocket Vertaling: Clavis Uitgeverij Vanaf 18 maanden / nur 271 / Kartonboek 8 pagina’s Formaat: 180 x 180 mm ISBN 978-9044850024 DE WERELD
Een schattig prentenboek over het seizoen waarin alles bloeit … De lente! Voor peuters vanaf 18 maanden, met de wereld rondom het kind als








Noortje voelt de eerste zonnestralen op haar gezicht. Er fladderen vlindertjes. Ze hoort de jonge vogel tjes piepen en knuffelt een pasgeboren lammetje. Samen met pop Bibi, Poes en hond Boef ontdekt Noortje hoe alles groeit en bloeit in de lente.

Prijs: € 12,95 isbn 978 90 448 3217 4 Prijs: € 12,95 isbn 978 90 448 2981 5 carnaval heeft een verkleedkist en carnavalspulletjes. of als brandweervrouw En dan vindt Noortje een kostuum dat perfect bij haar past. Een eenvoudig en herkenbaar verhaal over carnaval en verkleedplezier. Voor peuters vanaf 18 maanden, met de wereld rondom het kind als thema. Annemarie van der Heijden Noortje viert carnaval viert carnaval NOORTJE Clavis peuter Het is Pasen! NOORTJE beschildert paaseieren in vrolijke kleuren. In het kippenhok in de tuin liggen nog meer eitjes, maar dat zijn geen paaseitjes. Uit die eieren komen kuikentjes. En wat ligt er daar onder de struiken? Het zijn paaseitjes van chocolade! Een vertederend en vrolijk verhaal over een meisje en haar poes en hond, die samen Pasen vieren. Voor peuters vanaf 18 maanden, met de wereld rondom het kind als thema. Annemarie van der Heijden Noortje en de paaseitjes www.clavisbooks.com voor baby’s dagelijks leven vaardigheden de wereld taalontwikkeling Clavis peuter en de paaseitjes NOORTJE Clavis Uitgeverij 9 Een nieuw seizoen met Noortje Daar is de lente! Prijs: € 12,95 Verschijnt: februari 2023 isbn 978 90 448 5087 1 Titel: Noortje in de lente Serie: Noortje Auteur en illustrator: Annemarie van der Heijden (Wijchen) Vanaf 18 maanden / nur 271 / Geb. 24 pagina’s Formaat: 185 x 185 mm
Hmm, wat ruikt dat lekker!
Een nieuw boek van Anna
Een vrolijk verhaal over een bezoekje aan de bak ker. Voor peuters vanaf 30 maanden, met de wereld rondom het kind als thema.

Anna en mama moeten nog even naar de bakker, anders is er morgen geen brood om mee naar school te nemen. Hmm, wat ruikt het lekker in de winkel van de bakker! Anna heeft wel zin in iets lekkers …

Prijs: € 15,95 Verschijnt: maart 2023 isbn 978 90 448 5088 8
Titel: Anna bij de bakker Serie: Anna Auteur en illustrator: Kathleen Amant (Lede) Vanaf 30 maanden / nur 271 / Geb. 32 pagina’s Formaat: 210 x 220 mm ISBN 978-9044850888 DE WERELD


10
Clavis Uitgeverij











Clavis Uitgeverij 11 Anna in een nieuw jasje! Prijs: 15,95 isbn 978 90 448 2187 1 Verschijnt: december 2022 Achtste herziene druk Prijs: € 15,95 isbn 978 90 448 1061 5 Verschijnt: maart 2023 Prijs: € 15,95 isbn 978 90 448 0565 9 Verschijnt: maart 2023 Zeventiende herziene druk Prijs: 15,95 isbn 978 90 448 0838 4 Verschijnt: december 2022 Dertiende herziene druk Prijs: € 15,95 isbn 978 90 448 1035 6 Verschijnt: maart 2023 Zestiende herziene druk Kathleen Amant Anna en de paashaas Kathleen Amant Anna en de paashaas Clavis peuter Vandaag is het Pasen. Anna en haar broertje Lars zijn al vroeg wakker. Samen gaan ze paaseitjes zoeken. Waar zou de paashaas de eitjes verstopt hebben? Al snel vinden ze een heleboel chocolade-eitjes. En wat is het moeilijk om daar af te blijven … Een grappig verhaal over de zoektocht naar paaseitjes. Voor peuters vanaf 24 maanden, met de wereld rondom het kind als thema. www.clavisbooks.com voor baby’s vanaf 12 m. dagelijks leven vaardigheden emotie taalontwikkeling vanaf 18 m.
Samen lezen
den, met de taalontwikkeling van het kind als thema.


Kleine Kangoeroe beleeft avonturen met zijn vriendjes Kleine Buidelrat en Kleine Koala. Ze laten elkaar hun bij zondere staarten zien. Ze spelen verstoppertje met appels en gaan samen op zoek naar de kleur blauw. Bij elk van de drie verhalen in dit boek horen ook een grote zoekplaat en een grappige puzzel die je samen op kunt lossen.


Taalontwikkeling en speelplezier!
Met puzzel en zoekplaat. Voorbeeld uit Kleine Beer. Spelen in de sneeuw
met






talen, voor leergierige peuters vanaf 2 jaar.




in




buiten, ja, nee, mama, papa … In deze doos vind je 40 kaarten van de belangrijkste peuterwoordjes. Elke kaart beeldt het woord uit in een heldere tekening én geeft het woord weer in twintig verschillende talen. Ideaal als communicatiemiddel in de klas of als leermiddel thuis.





bonjour Frans hello Engels hallo Duits اًبحرم Arabisch hola Spaanscześć Pools ciao Italiaansनमस्ते Hindi 你好 merhabaChineesTurksпривет Russisch привіт Oekraïens γειά σου Grieksこんにちは Japans ولیہ Urdu mirëdita Albanees здравей Bulgaars ملاس Farsi bună Roemeens 13
in 20 talen!
Prijs: € 10,95 Verschijnt: maart 2023 ean 54 0700998 099 2 Titel: Woordjes van Milan Illustrator: Kathleen
(Lede) Vanaf 2 jaar Beluister de Nederlandse woordjes met de Clavis
Clavis Uitgeverij Herziene versie met meer woordjes en meer talen
Woordjes
Kaartjes
de belangrijkste peuterwoordjes
20
Binnen,
Amant
GO-app!
Daar is de lente
De wereld kleurt in vrolijke bloesemkleuren en de eerste zonnige dagen zijn daar. Tijd om naar buiten te trekken voor leuke spelletjes, heerlijke picknicks of een dagje werken in de tuin. Handen uit de mouwen!











Lentekriebels met Anna Een vrolijk, leerrijk en lekker dik boek over de lente. Voor kinderen vanaf 2,5 jaar. Ontdek de lente samen met Anna. Buiten wordt het warmer. Het zonnetje schijnt en de vogeltjes worden wakker. Wat een leuke deuntjes fluiten ze. Anna kan geen genoeg krijgen van de lente, in al haar geuren, kleu ren en melodieën! Prijs: € 20,95 Verschijnt: februari 2023 isbn 978 90 448 5092 5 Titel: Anna’s grote lenteboek Serie: Anna Auteur en illustrator: Kathleen Amant (Lede) Vanaf 2,5 jaar / nur 273 / Geb. 56 pagina’s Formaat: 250 x 260 mm ISBN 978-9044850925 Een nieuw seizoenenboek van Anna Clavis Uitgeverij 15
Een vrolijk en eenvoudig verhaal over de lente. Voor lentekindjes vanaf 3 jaar.




Het is lente! Luuk en Lotje gaan in de tuin spelen. De bomen hebben nieuwe blaadjes gekregen en de vogels maken een nest. Maar hé, wat piept er daar in de struiken? Een pluizig geel kuikentje! Wie zou de mama zijn? Zoek je mee met Luuk en Lotje?

ISBN 978-9044850949
Nieuwe versie op groter formaat
Tuinieren met Luuk en Lotje




Een heerlijke moestuinkalender met de beken de figuurtjes Luuk en Lotje van Ruth Wielockx. Voor kleine kinderen die grote stappen zetten.

Mijn moestuinkalender is een kalender van Luuk en Lotje voor jou. De twee weten als geen ander hoe je je eigen fruit en groenten kunt zaaien, planten en oogsten. Met behulp van een verhaal, stickertjes en een beetje geduld leer je zelf lekkers uit je eigen tuin toveren.

Prijs: € 9,95

Verschijnt: februari 2023 isbn 978 90 448 5076 5
Titel: Mijn moestuinkalender Serie: Luuk en Lotje Auteur en illustrator: Ruth Wielockx (Balen) Vanaf 3 jaar


Met stickers! Gebaseerd op dit boek! Er komt ook een gezelschapsspel van dit boek Clavis Uitgeverij 17 Prijs: € 17,95 isbn 978 90 448 4186 2
Kas en Saar in de

















Prijs: €
Prijs: € 14,95 Kathleen Amant Kathleen Amant Anna en haar groentetuintje Clavis peuter Anna en haar groentetuintje Prijs: € 17,95 Prijs: € 17,95 Clavis ‘Waarom hebben jullie laarsjes aan?’ vraagt opa verbaasd. ‘Het is heel mooi weer. Ik zie geen regen!’ ‘We gaan toch naar de moestuin?’ lacht Kas. ‘Dan moet je laarsjes aan, want van in de tuin werken word je lekker vies.’ De opa van Saar heeft een moestuin. Vandaag mogen Kas en Saar meehelpen. Ze wieden onkruid, planten pompoenen, zaaien spinazie en oogsten verschillende groenten en fruit. Als ze weer thuis zijn, maken ze een verse salade en schaaltjes vol rode aardbeien. Mmm, zo lekker! Een vrolijk en herkenbaar prentenboek over tuinieren in de moestuin. Voor kinderen met groene vingers vanaf 3 jaar. Kas en Saar in de moestuin Pauline Oud
Pauline Oud Clavis Clavis Groentjes uit eigen tuin! Muffin toont haar vriendje Konijn hoe je zaadjes plant. Samen helpen ze mama elke dag in de moestuin. Na een tijdje worden de zaadjes mooie grote planten. En dan … is het tijd om te oogsten! Een vrolijk en leerzaam boek over Muffin en haar moestuin. Voor lezers met groene vingers vanaf 4 jaar.
15,95
moestuin
De Moestuin van Muffin Sam Loman 18 Clavis Uitgeverij Naar de moestuin! De moestuin ontdekken nog leuker met een interactief boekje dat jonge kinderen uitnodigt om zelf de plaatjes te veranderen. Een leuk schuifboekje over de lekkere moestuin voor kinderen vanaf 1 jaar. Emiri Hayashi mijn schuifboekje Op pad in de moestuin ISBN 978-9044848182 www.clavisbooks.com Clavis de moestuin Sejer, Parijs, Frankrijk Nederlandse taalgebied: Alkmaar New York Promenadeaupotager Éditions Nathan, Sejer, Parijs dieren 4818 2 Emiri Hayashi Op pad in de moestuin mijn schuifboekje Prijs: € 17,95 isbn 978 90 448 1679 2 Prijs: € 19,95 isbn 978 90 448 3812 1
Sam Loman
www.clavisbooks.com

luistervinkjes vanaf 2 jaar.
Zet het knopje op ON om de geluidjes te kunnen horen.

Schroef het deksel van de batterijenhouder open met een schroevendraaier om batterijen Schroef de houder na vervanging weer goed dicht. De batterijen dit boekje zijn knoopbatterijen Laad batterijen niet op. Gebruik geen verschillende types batterijen oude en nieuwe batterijen door elkaar. Haal gebruikte batterijen het boekje. Raak het uiteinde van batterij niet aan met een metalen voorwerp om kortsluiting vermijden.
Anita Bijsterbosch Hoor de lente? Luister naar de vier seizoenen (geluidenboek) 2019 Clavis Uitgeverij, Hasselt Amsterdam New York Artistieke leiding: Sigrid Werck Sound design: Muziekstudio Clavis (Jorgo De Groof) Trefw.: bos, dieren, seizoenen, natuur D/2019/4124/004 Gedrukt in China www.anitabijsterbosch.nl












Het is lente! De vogels fluiten en de zon schijnt. Saar en oma gaan samen naar boer Koos. Daar ziet Saar allemaal kleine dieren: lammetjes, kuikens, kalfjes en eendjes. Wat zijn ze schattig! Saar en oma kopen eieren en plukken mooie bloemen. Maar de eieren van boer Koos zijn bijzonder. Heel bijzonder

Een vrolijk en herkenbaar prentenboek over de natuur in de lente. Voor kinderen vanaf jaar.
















Leve de lente! Teckel Tokkel geniet van de eerste warme zonnestralen op zijn snuit, fietstochtjes, paaseieren zoeken en naar de markt gaan met mama en Basiel. Ook in dit seizoen blijft Tokkel zijn ondeugende zelf: hij zaait paniek op de boerderij en doet een avondje visite in het honderd lopen. In de tuin ontluiken de eerste bloemen, maar ook tussen Tokkel en zijn vriendinnetje Trojka lijkt er iets moois te bloeien … Nog meer grappige en warme voorleesverhaaltjes over teckel Tokkel en zijn baasje Basiel, voor lezers en luisteraars vanaf vijf jaar, met of zonder ondeugende hondjes.


Ilse De Keyzer & Ina Hallemans

Prijs: € 15,95 isbn 978 90 448 3553 3 lente en zomer Kathleen Amant Kathleen Amant Anna en de lente De zon schijnt heerlijk vandaag. Het is lente! Anna trekt haar laarsjes aan en gaat op ontdekkingstocht in de tuin. Ze ziet bloesems aan de bomen, kleine vogels en pasgeboren lammetjes. Bij het kippenhok vinden Anna en haar buurjongen een chocolade ei. Wat gek! Zouden kippen chocolade eieren leggen in de lente? Eenvrolijkenleerrijkverhaalovereenstralendelentedag. Voorpeutersvanaf30maanden, met de wereld rondom het kind als thema. Anna en de lente voor baby’s dagelijks leven vaardigheden de wereld taalontwikkeling vanaf 24 m. Clavis peuter www.clavisbooks.com Clavis peuter Lente met Fien en Milo ISBN 978-9044835533 Pauline Oud Pauline
Lente met Fien en Milo CV_9789044835533.indd All Pages 26/11/18 14:13 Eekhoorn kijkt naar buiten. Hij ziet groene blaadjes aan de bomen en mooie bloemen in het gras. Het is lente. Eekhoorn hoort de kikkertjes kwaken en de vogeltjes fluiten. En hij hoort iemand zeggen: KOEKOEK-KOEKOEK Wie maakt toch dat vreemde geluidje? Een vrolijk geluidenboek over de wonderlijke natuur én een verstopte koekoek. Voor
Oud
Anita
Druk op de knop en luister naar de leukste geluiden van de lente, de zomer, de herfst en de winter! 11/12/18 10:57 Prijs: € 15,95 isbn 978 90 448 2187 1 Prijs: € 19,95 isbn 978 90 448 3453 6 17,95 978 90 448 3856 5 Prijs: € 17,95 isbn 978 90 448 4095 7 Prijs: € 15,95 isbn 978 90 448 0836 0 Prijs: € 17,95 isbn 978 90 448 2988 4 Prijs: € 17,95 isbn 978 90 448 4544 0 ruikt de lente Martine van Nieuwenhuyzen Martine van Nieuwenhuyzen Clavis ruikt de lente Saar in de lente Saar in de lente Pauline Oud Pauline Oud Clavis
Anita Bijsterbosch
Bijsterbosch
‘Ooo,’ roept Saar. De appelboom in oma’s moestuin is helemaal roze! ‘Die bloemetjes zijn bloesems,’ zegt oma. ‘Straks groeit uit elk bloemetje een appel. Dus je mag de bloemen niet plukken.’
www.clavisbooks.com
www.clavisbooks.com ISBN978-9044840957 Clavis
Ilse De Keyzer & Ina Hallemans Lentekriebels Lentekriebels met met Prijs: € 11,95 isbn 978 90 448 4535 8
de lucht Clavis Uitgeverij 19 Prijs: € 17,95 isbn 978 90 448 4545 7
Lente in
Vier je mee?
Een nieuw avontuur van Vos, Uil, Muis en Wasbeer!
Een vrolijk en interactief prentenboek waarin Vos, Muis, Wasbeer en Uil Pasen vieren. Voor kinderen



Vos, Muis, Wasbeer en Uil tellen af naar Pasen. Samen gaan ze op zoek naar paaseitjes in alle kleu ren van de regenboog. Maar die eitjes zijn wel heel goed verstopt. Of zijn er geen dit jaar? Kun jij helpen?
Prijs: € 17,95
Verschijnt: februari 2023 isbn 978 90 448 5097 0
Titel: Paaspret Auteur en illustrator: Anita Bijsterbosch (Brummen) Vanaf 3 jaar / nur 273 / Geb. 32 pagina’s Formaat: 250 x 260 mm ISBN 978-9044850970

Prijs: € 17,95 isbn 978 90 448 4329 3

Wat is dat, Pasen?


Een eenvoudig paasverhaal met vrolijke pren ten. Voor kinderen vanaf 3 jaar. er weg in het bos staat een huisje. Daar woont de paashaas, tussen het groen. Als het na de lange winter bijna Pasen is, wordt het voor hem een drukke tijd.

Ideaal als voorbereiding op het paasfeest

Clavis Uitgeverij 21
Prijs: € 17,95 Verschijnt:
2023 isbn 978 90 448 5096 3 Titel: Piep,
Auteur en illustrator:
Vanaf 3 jaar / nur 273 / Geb. 32 pagina’s Formaat: 290 x 210 mm ISBN 978-9044850963
januari
het is Pasen!
Liesbet Slegers (Herentals)
Pasen in de klas
Een herkenbaar en vrolijk prentenboek over Pasen. Voor kleine paashazen vanaf 3 jaar.


Vandaag is het een bijzondere dag. Het is Pasen. In de klas spelen Kas en Saar allerlei leuke spelletjes en knutselen ze paasversiering. Wie komt daar de klas binnen? Een echte paas haas! Hij neemt de kinderen mee naar het park. Daar zien ze lammetjes en kuikentjes. Maar zouden er ook paaseitjes zijn?

Prijs: € 17,95
Verschijnt: februari 2023 978 90 448 5098 7
Titel: Kas en Saar vieren Pasen Serie: Kas en Saar Auteur en illustrator: Pauline Oud (Bilthoven) Vanaf 3 jaar / nur 273 / Geb. 32 pagina’s Formaat: 250 x 260 mm ISBN


978-9044850987












Clavis Uitgeverij 23 23 Vrolijk Pasen! Clavis Mieke Goethals Prijs: € 17,95 isbn 978 90 448 1910 6 Achtste druk februari 2023 iane R ulf Clavis Op een mooie lenteochtend vindt Lotta grote, kleurige eieren in het gras. Welke kip legt nu zulke eieren? Dan komt de paashaas aangefietst. In de wei liggen natuurlijk geen gewone eieren, maar paaseitjes van chocola. De paashaas en de kip worden goeie maatjes. Lotta maakt niet alleen de paashaas blij, maar ook de kuikentjes! Prentenboek nummer vijf over de vrolijke kip Lotta is een lentefris paasboek met Lotta, de paashaas én humor in de hoofdrollen. Vanaf 3 jaar. www.clavisbooks.com Diane Put & Rik De Wulf LOTTA en de paashaas L otta en de paashaas Prijs: € 17,95 isbn 978 90 448 3224 2 Prijs: € 19,95 isbn 978 90 448 3858 9 Prijs: € 18,95 isbn 978 90 448 3854 1 Prijs: € 12,95 isbn 978 90 448 2981 5 Clavis peuter Prijs: € 17,95 isbn 978 90 448 3561 8 Prijs: € 15,95 isbn 978 90 448 1905 2 Prijs: € 17,95 isbn 978 90 448 3318 8
Een vrolijk boek over een zomerse dag aan het strand. Voor zonnestraaltjes vanaf 3 jaar.

Koenijn wordt wakker op een zonnige ochtend. Hij staat op en rent naar de slaapkamer van mama. ‘Wakker worden, mama, we gaan naar het strand vandaag!’ Koenijn kan niet wachten om de zee in te duiken!
Prijs: € 17,95 Verschijnt: april 2023 isbn 978 90 448 5090 1 Titel: Koenijn duikt de zomer in Serie: Koenijn Auteur en illustrator: Martine van Nieuwenhuyzen (Ulvenhout) Vanaf 3 jaar / nur 273 / Geb. 32 pagina’s Formaat: 250 x 260 mm




Clavis Uitgeverij
ISBN 978-9044850901
Een vrolijk en herkenbaar verhaal over mooie zomerdagen. Voor dierenvriendjes vanaf 3 jaar.
Vosje Vic heeft zo lang uitgekeken naar de zomer. Hij heeft een vlieger gemaakt, en hij kan niet wachten om hem uit te testen. Maar … er is geen zuchtje wind. Misschien weten de vriendjes wel een manier om de vlieger de lucht in te krijgen?


Prijs: € 17,95
Verschijnt: april 2023 isbn 978 90 448 4736 9
Titel: Klaar voor de zomer Serie: Vosje Vic en vriendjes Auteur: Federico Van Lunter (Tongeren) lllustrator: Katya Longhi Vanaf 3 jaar / nur 273 / Geb. 32 pagina’s Formaat: 250 x 260 mm


25 Clavis Uitgeverij
ISBN 978-9044847369
Thuis in de natuur


Een prachtig natuurboek vol tips en zoekplaten. Voor kinderen met een hart voor de natuur vanaf

Hop en Dop houden van de natuur. Van de lente, als alles weer mooi groen kleurt en de dieren uit hun winterslaap ontwaken. Van de zomer, als alles zoemt en bloeit in de weilanden rondom het magi sche bos. En van de herfst, als de blaadjes aan de bomen prachtig verkleuren! In de winter zijn alle dieren en bomen goed voorbereid op de kou. Zo bijzonder! Duik samen met Hop en Dop in het magische verhaal van de vier seizoenen.
Prijs: € 19,95 Verschijnt: april 2023 978 90 448 5091 8
Titel: Door de seizoenen met Hop en Dop Serie: Magisch mooi Auteur en illustrator: Margot Senden (Mechelen) Vanaf 4 jaar / nur 273, 274 / Kartonboek 18 pagina’s Formaat: 260 x 340 mm ISBN





Clavis Uitgeverij 26
978-9044850918

Tijd voor een feestje
Het hele jaar door vieren we grote en kleine gebeurtenissen. Verjaardagen, geboortes, carnaval of moeder- en vaderdag. Alle redenen zijn goed voor een feestje!

Een avontuurlijk prentenboek vol piraten, zee vaarders en schatkisten. Voor kinderen met zeebenen vanaf 3 jaar.



Hoe word je een piraat? Kaatje neemt je mee in een spannend boek met ongelooflijke piraten verhalen en weetjes over het leven op zee. Durf jij je piratendiploma te behalen?
Verschijnt: april 2023 978 90 448 5095 6
Titel: Schip ahoi! Kaatjes grote piratenboek

Auteur en illustrator: Liesbet Slegers (Herentals) nur 273 / Geb. 56 pagina’s
250 x 260 mm

29 Clavis Uitgeverij
Formaat:
Prijs: € 18,95 isbn 978 90 448 5022 2 Karel wordt ridder ISBN 978-9044850956
Zet het knopje op ON om de geluidjes te kunnen horen.

















Schroef het deksel van de batterijenhouder open met een schroevendraaier om de batterijen eruit te halen erin te stoppen. Schroef de houder na vervanging weer goed dicht. De batterijen dit boekje zijn knoopbatterijen 10. Laad batterijen niet op. Gebruik geen verschillende types batterijen of oude nieuwe batterijen door elkaar. Plaats de batterijen de juiste richting (+/-). Haal gebruikte batterijen uit het boekje. Raak het uiteinde van de batterij niet aan met een metalen voorwerp om kortsluiting te vermijden.



Prijs: € 17,95 isbn 978 90 448 3571 7 Prijs: € 9,95 isbn 978 90 448 1840 6 978 90 448 4947 9 Prijs: € 19,95 isbn 978 90 448 3765 0 Clavis BOBBIE
Verkleden met Bobbie (geluidenboek) 2021 Clavis Uitgeverij, Artistieke
Sigrid
978-9044837650
leiding:
Werck Sound design: Muziekstudio Clavis (Jorgo De Groof) Stem Bobbie: Elmo De Groof Trefw.: verkleden, kleding, plezier maken Gedrukt in China
Prijs: € 17,95 isbn 978 90 448 2994 5 Zesde druk januari 2023 Prijs: € 9,95 isbn 978 90 448 2640 1 Prijs: € 12,95 isbn 978 90 448 3217 4 Prijs: € 17,95 isbn 978 90 448 3277 8 Vijfde druk december 2022 De leukste carnavalsboeken Anna viert carnaval Vandaag is het carnaval. Anna is verkleed als clown. Samen met papa gaat ze naar het carnavalsfeest. Daar ziet ze een mooie optocht. Iedereen heeft veel plezier. Feest jij met Anna mee? Eenvrolijkverhaaloverhetvierenvancarnaval. Voorpeutersvanaf24maanden,metdewereld rondom het kind als thema. www.clavisbooks.com voor baby’s dagelijks leven vaardigheden de wereld taalontwikkeling vanaf 24 Prijs: € 15,95 isbn 978 90 448 0692 2






























Ik hou van jou! Prijs: € 17,95 isbn 978 90 448 3981 4 Prijs: € 17,95 isbn 978 90 448 3633 2 Prijs: € 17,95 isbn 978 90 448 4786 4 Tweede druk december 2022 Prijs: € 17,95 isbn 978 90 448 4229 6 Prijs: € 29,95 isbn 978 90 448 2939 6 Clavis Pimm van Hest & Sassafras De Bruyn Beer is verliefd Sam Loman ISBN978-9044836332 voor de deur van Eekhoorn. ISBN 978-9044847864 Clavis Ron van Maurik Ron van Maurik Ik heb je lief zoals je bent Egel en muis zijn vrienden. Beste vrienden. Als ze spelen, maakt het niet uit wat ze doen, als ze het maar samen doen. Op een dag wil Egel tegen Muis zeggen dat hij zo blij is met hem als vriend. Maar … hij struikelt en landt recht op Muis. Dat prikt! Zou Muis niet blijer zijn met een zachte vriend, in plaats van een met stekels? Een ontroerend verhaal over vriendschap en jezelf kunnen zijn. Voor kinderen vanaf 4 jaar. Prijs: € 15,95 isbn 978 90 448 4326 2 31 Clavis Uitgeverij Tips voor Valentijn
Zeg het met een kaartje
Doosjes van telkens tien kaartjes voor verschillende gelegenheden. Verjaardag, moederdag of gewoon, zomaar?




















Een kaartje met een paar lieve zinnen is fijn om te krijgen én te geven!






Prijs: € 14,95
Verschijnt: februari 2023 ean 54 0700998 095 4
Verjaardagskaartjes Rikki


Illustrator: Guido Van Genechten (Mol)


























Formaat: 105 x 148 mm 2 x 5 kaartjes






























































Prijs: € 14,95
Verschijnt: februari 2023 ean 54 0700998 096 1
Verjaardagskaartjes Varkentje Illustrator: Francesca Pirrone Formaat: 105 x 148 mm 2 x 5 kaartjes










Prijs: € 14,95
Verschijnt: februari 2023 ean 54 0700998 094 7
Kaartjes Mama Illustrator: Quentin Gréban Formaat: 105 x 148 mm 2 x 5 kaartjes
Prijs: € 14,95































Verschijnt: februari 2023 ean 54 0700998 097 8
Kaartjes Dank je wel
Illustrator: Rik de Wulf (Dilbeek) Formaat: 105 x 148 mm 2 x 5 kaartjes





































© 2022 Clavis Uitgeverij, Hasselt – Alkmaar – New York, illustraties van Rik De Wulf ©2022ClavisUitgeverij,Hasselt-Alkmaar-NewYork,illustratiesvanAnLeysen ©2022ClavisUitgeverij,Hasselt–Alkmaar–NewYork,illustratiesvanGuidoVanGenechten ©2022ClavisUitgeverij,Hasselt-Alkmaar-NewYork,illustratiesvanRuthWielockx
leuke stickers!
Met
Anna is vandaag alleen thuis met papa. Het wordt een heel leuke papa-dag. Anna en papa voetballen in de tuin en spelen een spelletje. Maar ze doen samen ook allerlei


































De beste mama’s en papa’s Prijs: € 15,95 isbn 978 90 448 1907 6 Prijs: € 17,95 isbn 978 90 448 0899 5 Prijs: € 17,95 isbn 978 90 448 3377 5 Prijs: € 17,95 isbn 978 90 448 4034 6 Kathleen Amant Kathleen Amant Anna en haar lieve mama Anna heeft de liefste mama van de hele wereld. Als mama en Anna een dagje alleen zijn, doen ze leuke dingen samen. Ze fietsen gezellig naar de winkel, bakken een heerlijke taart en doen de was. Maar hé, Konijn is in de wasmachine gekropen! Anna is een beetje sip, Konijn ziet er gek uit nu … Gelukkig vrolijkt mama Anna weer op, zoals alleen zij dat kan! EenvrolijkverhaaloverAnnaenhaarmama. Voorpeutersvanaf30maanden, met de emoties van het kind als thema. Anna en haar lieve mama voor baby’s dagelijks leven vaardigheden emotie taalontwikkeling vanaf 18 m. vanaf 30 m. Clavis peuter www.clavisbooks.com Hélène Delforge & Quentin Gréban Clavis Hélène Delforge & Quentin Gréban Clavis Ze doen ook maar gewoon hun best, Papa’s zijn soms … 10/04/19 14:33
Kathleen Amant
Kathleen Amant Anna en haar lieve papa
klusjes: strijken, het gras maaien, boodschappen doen … Wat hebben papa en Anna het druk! Als het eten klaar is en de tafel gedekt, rusten ze even uit op de bank. Wat zijn ze moe … Eenherkenbaarverhaalovereendagjealleenzijnmetpapa. Voorpeutersvanaf30maanden, met de emoties van het kind als thema. Anna en haar lieve papa voor baby’s dagelijks leven vaardigheden emotie taalontwikkeling vanaf m. vanaf 30 m. Clavis peuter www.clavisbooks.com Clavis papa! Doe eens een kikker na, G U DEN BO K GELU DEN BOEKJE Doe eens een kikker na, papa! Clavis www.clavisbooks.com ISBN:978-9044808995 Als mama even weg moet, zorgt papa voor de kinderen zoals alleen hij dat kan. Binnen de kortste keren wordt het een vrolijke bende. Alles kan en alles mag. Wat zou mama daarvan vinden? Dit grappige prentenboek laat zien dat papa’s net zo goed op hun kinderen kunnen passen als mama’s. (Maar wel op hun manier, natuurlijk …) Voor kinderen vanaf 3 jaar én hun papa’s. Prijs: € 24,95 isbn 978 90 448 3282 2 Prijs: € 17,95 isbn 978 90 448 2992 1 Prijs: € 19,95 isbn 978 90 448 3654 7 Prijs: € 15,95 isbn 978 90 448 1908 3 Prijs: € 19,95 isbn 978 90 448 3846 6 Klein wit visje heeft een heleboel vriendjes. En allemaal hebben ze een fantastische papa ene is supersterk, de andere de allergrootste en weer een andere papa is keislim of reuzegrappig Natuurlijk is ook de papa van Klein wit visje ergens heel erg goed in. Een hartverwarmend boek voor kleine bewonderaars vanaf 2,5 jaar én hun papa’s. www.clavisbooks.com Klein wit visje Klein wit visje en zijn papa Guido van Genechten en zijn papa Guido van Genechten p p 33 Clavis Uitgeverij Prijs: € 7,95 isbn 978 90 448 3053 8
Talent
Geloof in jezelf. Als iemand het kan, ben jij het wel! Want jij hebt talenten die jou helemaal uniek maken.

Een lief verhaal over vriendschap die blijft bestaan, ook al zijn alle vrienden anders. Voor vosjes vanaf




Beer en Eekhoorn willen niet meespelen met Vosje. Dat maakt hem verdrietig. Er is toch niks leukers dan in kleine holletjes kruipen en sporen zoeken? Misschien zijn mijn vrienden en ik te verschillend, denkt Vosje … Gelukkig heeft mama een idee.

Prijs: € 17,95
Verschijnt: februari 2023 978 90 448 5047 5
Titel: Vriendjes

Auteur: Mark Janssen (Valkenburg aan de Geul)
Illustrator: Suzanne Diederen (Valkenburg aan de Geul) Vanaf 3 jaar / nur 273 / Geb. 32 pagina’s Formaat: 250 x 260 mm
35
Clavis Uitgeverij
Over talenten
Op zoek naar een tovertalent
ISBN 978-9044850802


Een magisch prentenboek over een heksje dat op zoek gaat naar haar unieke talent. Voor draakjes en tovenaars vanaf 4 jaar.
Lexia heeft één grote droom: ze wil een echte toverheks worden, net zoals haar grote zus. Maar om te slagen voor de toelatingsproef moet ze wel een speciaal hek sentalent hebben. Lexia doet haar uiterste best, maar niet alles verloopt volgens plan. Zal ze ooit een goede dierenheks worden, of een heks met groene vingers?
Prijs: € 19,95
Verschijnt: april 2023 isbn 978 90 448 5080 2
Titel: Heks Lexia en de toverproef

Auteur: Liesbeth Iken (Schoten) Illustrator: Christiaan Iken (Schoten)

Vanaf 4 jaar / nur 273 Geb. 32 pagina’s Formaat: 235 x 325 mm

Meer van dit duo En van deze illustrator


Prijs: € 17,95 isbn 978 90 448 4511 2
Prijs: € 17,95 isbn 978 90 448 3828 2

36 Clavis Uitgeverij
Een prachtig prentenboek over niet kunnen, maar gelukkig ook weer wel. Voor kinderen
Kam is een vrolijk visje. Maar kan ze ook vliegen, stappen
Krak de krokowil kijkt verbaasd naar de capriolen van Kam. Gelukkig ontdekt Kam samen met Krak wat ze wel goed kan. ISBN


Prijs: € 17,95 Verschijnt: april 2023 isbn 978 90 448 4369 9

Titel: Kam de kanvis Serie: Lieve het leerbeestje Auteur: Bart Van Puyenbroeck (Genk) Illustrator: Jessica Raes (Opwijk) Vanaf 4 jaar / nur 273 / Geb. 32 pagina’s Formaat: 250 x 260 mm




37 Clavis Uitgeverij 37
978-9044847093
Meer in deze reeks Prijs: € 17,95 isbn 978 90 448 4088 9 Prijs: € 17,95 isbn 978 90 448 4118 3 Prijs: € 17,95 isbn 978 90 4488 4227 2
Over winnen en verliezen
ISBN 978-9044849950
Een lief verhaal over winnen en verliezen, en de mooiste prijs van allemaal: vriendschap! Voor klei ne kunstenaars vanaf 4 jaar.

Varkentje heeft een prachtig schilderij gemaakt. Hij is er zo blij mee dat hij het wil insturen voor een wed strijd. Maar dan gebeurt er een ongelukje: varkentjes kunstwerk wordt vernield, en dat maakt hem ver drietig. Gelukkig kunnen zijn vrienden hem troosten door samen met hem te schilderen.
Prijs: € 17,95 Verschijnt: maart 2023 978 90 448 4995 0
Titel: En de winnaar is … Serie: Varkentje Auteur en illustrator: Francesca Pirrone Oorspronkelijke titel: The winner is … Vertaling: Clavis Uitgeverij Vanaf 4 jaar / nir 273 / Geb. 32 pagina’s Formaat: 210 x 290 mm





Meer van Varkentje
Prijs: € 17,95 isbn 978 90 448 4706 2
Prijs: € 17,95 isbn 978 90 448 4688 1
38 Clavis Uitgeverij
Daar zit muziek in
Een vrolijk boek over onverwachte talenten ontdekken als je denkt dat je er geen hebt. Voor muzikale stampertjes vanaf 4 jaar.

Toby droomt ervan om met de merels mee te zingen. Maar wanneer zijn droom einde lijk werkelijkheid wordt, rent iedereen weg, zo vreselijk klinkt zijn gezang! Teleurgesteld vlucht Toby het bos in, want hij zal nooit mooie muziek kunnen maken … Toch?
Prijs: € 17,95
Verschijnt: maart 2023 isbn 978 90 448 4556 3
Titel: Een bos vol muziek
Auteur: Suzan Overmeer (Leidschendam)
Illustrator: Myriam Berenschot (Groningen)
Vanaf 4 jaar / nur 273 / Geb. 32 pagina’s Formaat: 210 x 290 mm

39 Clavis Uitgeverij
Iedereen heeft een talent!
ISBN 978-9044845563
Het derde boek over
Een lief verhaal vol humor, over vriendschap en doorzettingsvermogen. Voor vosjes en muisjes vanaf 5 jaar.
In de boom hangt een mooie rode ballon. Hij hangt hoog, heel hoog. Borre en zijn vriendjes kunnen er niet bij. Zelfs niet als ze spingen. En ook niet als ze op elkaar gaan staan.
Was er maar een manier om de ballon te pakken. Maar wacht eens, komt Uil daar aan?
18,95
Verschijnt: maart 2023 978 90 448 4774 1
Titel: Net als Uil

Serie: Borre en zijn vriendjes Auteur: Margreet Schouwenaar (Heiloo) Illustrator: Daniëlle Schothorst (Steenwijk) Vanaf 5 jaar / nur 273 / Geb. 40 pagina’s Formaat: 210 x 290 mm



Clavis Uitgeverij 40
verhalen over Borre Prijs: € 17,95 isbn 978 90 448 4083 4 Prijs: € 17,95 isbn 978 90 448 4491 7
Meer
Een muisje met een groot hart

Overoverwinnenangsten

Een lief verhaal over een muis die zijn grootste angst overwint om een ander te helpen. Voor moedige muisjes vanaf 5 jaar.
Leon is een muis met een groot hart. Als een vrouw op een dag haar sleutels kwijtraakt, brengt Leon ze naar haar terug. Omdat hij merkt dat de vrouw vaak dingen kwijtraakt, helpt hij haar steeds vaker. Maar wanneer de muis en de vrouw op gevaar stoten in de straten van Venetië, moet Leon al zijn moed bijeenrapen om te hulp te schieten.


Titel: Leeuwenhart Auteur en illustrator: Maya Onodera Oorspronkelijke titel: Löwenherz Vertaling: Clavis Uitgeverij Vanaf 5 jaar / nur 273 / Geb. 40 pagina’s Formaat: 210 x 290 mm ISBN 978-9044847529
Prijs: € 18,95 Verschijnt: maart 2023 isbn 978 90 448 4752 9

41 Clavis Uitgeverij
Een helpende hand

Niets is zo belangrijk voor kinderen als de liefde van hun ouders of verzorgers. Maar ook zij kunnen af en toe wat hulp gebruiken. Bij moeilijke momenten of spannende uitdagingen kan een boek nét dat beetje extra bieden.

Tweede boek in de serie
Beertje gaat op schoolreis
Een grappig en geruststellend boek over een schoolreisje met de klas. Voor dappere speelbeertjes vanaf 3 jaar.
Wat een leuke dag! Vandaag ga je op schoolreis. Dat is een leuk dagje uit … met de hele klas! Spannend, hè? Maar je hoeft je geen zorgen te maken, Beertje. Want ik zal je alles vertellen.

Prijs: € 17,95
Verschijnt: februari 2023 isbn 978 90 448 4913 4

Titel: Beertje Probeertje gaat op schoolreis Serie: Beertje Probeertje Auteur: Clavis Uitgeverij Illustrator: Eline van Lindenhuizen (Zwolle) Vanaf 3 jaar / nur 273 / Geb. 32 pagina’s Formaat: 250 x 260 mm ISBN 978-9044849134



Wat spannend! Misschien ga jij voor het eerst logeren, voor het eerst naar de dokter, of voor het eerst op schoolreis … Wat jouw avontuur ook is, Beertje Probeertje gaat met je mee. Maar eerst probeert hij het zélf een keertje uit. Zo zijn jullie allebei klaar voor de grote dag.

Meer in deze serie
Prijs: € 17,95 isbn 978 90 448 4882 3

43 Clavis Uitgeverij
Als moeilijkbedtijd is
Een verhaaltje voor het slapengaan
Een herkenbaar, grappig verhaal over een nacht je logeren bij oma en opa. Voor wakkere mon sters en slaapkopjes vanaf 3 jaar.
Monster Mo gaat logeren bij oma en opa, maar hij kan niet slapen. Hij probeert van alles, maar niets lijkt te helpen: van dieren tellen wordt hij nog wakkerder, en de maan en de sterren schijnen te fel. Gelukkig heeft opa nog één laatste idee. Een idee dat Mo heel goed uitkomt.
17,95


Verschijnt: april 2023 978 90 448 5050 5
Titel: Monster Mo kan niet slapen Serie: Monster Mo Auteur: Li Lefébure (Maastricht) Illustrator: Stefani Buijsman (Apeldoorn) Vanaf 3 jaar / nur 273 / Geb. 32 pagina’s Formaat: 250 x 260 mm



Nog meer Monster Mo

Prijs: € 17,95 isbn 978 90 448 4717 8 Prijs: € 17,95 isbn 978 90 448 4557 0
Clavis Uitgeverij
Eerste deel in een nieuwe serie
Een grappig verhaal over rommel maken en rommel opruimen. En over monsters, natuurlijk. Voor kinderen vanaf 4 jaar.



Roki is een echt rommelmonster. Want overal waar Roki komt, is er rommel. Rommel en rotzooi en troep en knoeiboel. Maar dat is niet altijd even fijn …

Verschijnt: februari 2023 978 90 448 4709 3


45 Clavis Uitgeverij
Iedereen is welkom



Prijs: € 17,95 Verschijnt: februari 2023 isbn 978 90 448 5081 9


Titel: Kleine Tractor leert delen Serie: Kleine Tractor Auteur: Natalie Quintart (Brussel) Illustrator: Philippe Goossens (Brussel)

Clavis Uitgeverij 46
ISBN 978-9044850819









47 Clavis Uitgeverij
Prijs: € 17,95 isbn 978 90 448 4338 5 Prijs: € 17,95 978 90 448 4552 5 Prijs: € 17,95 isbn 978 90 448 4951 6 Prijs: € 17,95 isbn 978 90 448 4187 9
Kleine tractor heeft veel emoties
En toen was je verdwenen
Prachtige taal, prachtige tekeningen
Een kwetsbaar prentenboek over afscheid en loslaten. Voor iedereen vanaf 5 jaar.
ik dacht dat ik je ging missen omdat je een leegte achter zou laten een gat in de vorm van je lach maar je bleef, toen je verdween
misschien is missen niet dat ik je niet meer zie maar dat ik je blijf zien waar je niet meer bent
Prijs: € 17,95 Verschijnt: mei 2023 isbn 978 90 448 4710 9 Titel: Ik mis je Auteur: Rik Peters (Sittard-Geleen) Illustrator: Federico Van Lunter (Tongeren) Vanaf 5 jaar / nur 273 / Geb. 32 pagina’s Formaat: 210 x 290 mm ISBN 978-9044847109


Clavis Uitgeverij
48
Over rouwverwerking
Een troostend doosje
Een warm prentenboek dat troost kan bieden aan families die een kindje verliezen. Voor iedereen vanaf 5 jaar.

Baby Bel is doodgegaan in de buik van mama Beer. Iedereen is verdrietig, en het is tijd om afscheid te nemen. Kleine Beer wil graag herin neringen aan zijn babyzusje bewaren, maar hoe verzamel je herinneringen aan iemand die niet oud is geworden? Gelukkig komt Kleine Beer na een bezoek aan oma op een goed idee.

17,95
Verschijnt: mei 2023 978 90 448 4999 8
49 Clavis Uitgeverij
Dromen van de mooiste jurk


Over gender en identiteit bij kleine kinderen


Een warm verhaal over zijn wie je bent, ook al is dat niet altijd gemakkelijk. Voor iedereen vanaf 5 jaar die houdt van een beetje glitter.
Van de blogster Wonderlandbyalice!

Clavis Uitgeverij 50
Over grenzen






Zoveel emoties
Hoe voel jij je vandaag?
Zoveel situaties en zoveel emoties. Boeken helpen kinderen om hun gevoelens te herkennen en te benoemen.
Zo wordt elke ervaring bespreekbaar. Boos, blij, verdrietig? Het mag allemaal.

Een warme ode aan alle oma’s
Ideaal als geschenkboek
Een prentenboek vol kleurrijke en heerlijk geurende herinneringen. Voor iedereen vanaf 5 jaar.
Oma heeft al meer herinneringen verzameld dan jij en ik samen. Ook oma was ooit een baby, een meisje, een vrouw. En dat hele leven draagt ze altijd met zich mee. Oma ruikt heerlijk. Ze ruikt naar …. Oma!

Vanaf 5 jaar / nur 273 Geb. 32 pagina’s Formaat: 210 x 290 mm ISBN 978-9044849110

Prijs: € 17,95 Verschijnt: maart 2023 isbn 978 90 448 4911 0 Titel: Niemand zoals oma Auteur en illustrator: Ellen Lambrichts (Antwerpen)


53 Clavis Uitgeverij
Van de winnaar van de Astrid MemorialLindgren Award
Een grappig boek met een vleugje spanning. Voor iedereen vanaf 5 jaar.
‘Stop!’ roept de wolf. ‘De brug verderop is afgesloten.’
‘Wat vervelend, ik moest juist die kant op,’ zucht het varkentje.
‘Kom maar lekker een kopje koffie drinken tot de brug gemaakt is,’ zegt de wolf.
En zo komt het varkentje terecht in de woon kamer van twee wolven. Komt dat wel goed?
ISBN 978-9044848977
Prijs: € 17,95 Verschijnt: maart 2023 isbn 978 90 448 4897 7
Titel: De brug Auteur en illustrator: Eva Lindström Oorspronkelijke titel: Bron Vertaling: Mijke Hadewey van Leersum (Oosterend) Vanaf 5 jaar / nur 273, 274 Geb. 32 pagina’s Formaat: 225 x 250 mm


Wanneer een vlinder en een bij botsen
Over mindfulness en het vlindereffect

Een poëtisch verhaal over hoe alles met elkaar in verbinding staat, en de impact van onze keu zes op anderen. Voor kinderen vanaf 5 jaar.
Een vlinder botst met een bij. Zonder dat de vlinder het weet, zet haar reactie op die botsing een hele reeks aan gebeurtenissen in gang, die leiden tot chaos op de boerderij.
17,95
Verschijnt: februari 2023 978 90 448 4903 5
Titel: Het begon bij de vlinder Auteur: Nicole Castrovinci


Illustrator: Madelon Koelinga (Waddixveen)

55 Clavis Uitgeverij
Over ziekte en hoop

Een meisje en een paard
Een inspirerend verhaal over een jong meisje en een paard. Voor kinderen vanaf 5 jaar.

Sara is ziek en haar benen werken niet meer goed. Als ze op een dag naar het ziekenhuis gaat voor haar behandeling, ziet ze in de wei een paard helemaal alleen staan in de regen. Het lijkt wel of Sara en het paard onmiddellijk een connectie hebben, en na lang aandringen mag ze naar het paard toe. Vanaf dat moment gaat Sara elke dag op bezoek, en zo ontstaat een erg bijzondere band.
Prijs: € 17,95
Verschijnt: april 2023 isbn 978 90 448 4904 2
Titel: Sara en het paard Auteur: Jim Stramler Illustrator: Ina Hallemans (Herselt)
Oorspronkelijke titel: Sara and the Lonely Horse Vertaling: Clavis Uitgeverij Vanaf 5 jaar / nur 273 / Geb. 32 pagina’s Formaat: 250 x 260 mm

56 Clavis Uitgeverij
ISBN 978-9044849042
Over jezelf zijn
Klein maar dapper
Een hartverwarmend prentenboek over een knuffel met een leeuwenhart. Voor dappere kinderen vanaf 5 jaar.
Het leven van knuffelleeuw Leroy is prachtig. Hij mag overal mee naartoe en hij krijgt elke dag wel duizend knuffels. Ja hoor, Leroy heeft het ontzettend naar zijn zin. Tot hij op tv een documentaire ziet over leeuwen in het wild. Is het leven van Leroy niet te braaf? Hoe zou het zijn om als een echte leeuw te leven?
Prijs: € 17,95
Verschijnt: februari 2023 isbn 978 90 448 4755 0
Titel: De knuffelkoning Auteur: Krista Legge Illustrator: Natallia Bushuyeva Oorspronkelijke titel: Leroy, King of Lions ISBN 978-9044847550


57 Clavis Uitgeverij
Het bos is van ons!
Een uniek, maar universeel verhaal over de zoek tocht naar een veilige plek. Voor kinderen vanaf 6 jaar.






De haas en de twee eekhoorns zijn beste vrien den. Ze haten jagen, en het enige wat ze willen is in vrede hun nootjes verstoppen. Maar op de dorpsvergadering stemt iedereen behalve zij vóór de jacht in het bos.
Prijs: € 17,95
Verschijnt: januari 2023 isbn 978 90 448 5042 0

Van de winnaar van de Astrid MemorialLindgren Award Genomineerd
Titel: Jaag niet op ons Auteur en illustrator: Eva Lindström Oorspronkelijke titel: Jaga inte oss Vertaling: Mijke Hadewey van Leersum (Oosterend) Vanaf 6 jaar / nur 273, 274 / Geb. 32 pagina’s Formaat: 175 x 200 mm




58 Clavis Uitgeverij
978-9044850420
ISBN
voor de August Prize, de belangrijkste boekenprijs in Zweden
Herkenbare verhalen
Een bundel met herkenbare, ontroerende en grappige verhalen en gedichten van elke dag. Voor kinderen vanaf 5 jaar.
Puck en Arend wonen in twee huizen: meestal bij mama en soms bij papa. Maar waar ze ook wonen, overal zijn avonturen te beleven. Puck en Arend lachen, huilen, maken ruzie, zijn stout, bang of boos. Maar ze vinden elkaar én hun mama en papa (meestal) heel erg lief!
Prijs: € 26,95
Verschijnt: februari 2023 isbn 978 90 448 4792 5

Titel: Hartjes met een kus Auteur: Mieke van Hooft (Wageningen) Illustrator: Marijn van der Wateren (Haarlem) 273 / Geb. 120 pagina’s




59 Clavis Uitgeverij
Spelenderwijs leren
Hoeveel bloemen zie je op de tekening? Herken je alle dieren? En welke kleur heeft de jas van het meisje?
Wees nieuwsgierig en elk boek maakt je slimmer.

Onderweg met Beestenboel
Eerste conceptboek in de succesreeks!Beestenboel-

Een speels boek vol voertuigen en hun beestige bestuurders! Voor kleine buschauffeurs en kapiteins vanaf 3 jaar.
Een vuilniswagen, een ijskarretje of een duikboot … Waarvoor dienen die eigenlijk? En wie zijn de bestuurders? Emma, Louis, Olivia en Arthur ont dekken samen met jou de leukste voertuigen. Klaar om te vertrekken?
Prijs: € 20,95
Verschijnt: februari 2023 isbn 978 90 448 4847 2
Titel: Iedereen onderweg! Het grote voertuigenboek Serie: Beestenboel Auteur en illustrator: Federico Van Lunter (Tongeren) Vanaf 3 jaar / nur 273 / Geb. 56 pagina’s Formaat: 250 x 260 mm
61 Clavis Uitgeverij
ISBN 978-9044841886
Vroem vroem, tuuut tuuut!
Vormen om mee te spelen
Creatief spelenderwijsenleren
Een vrolijk boek vol kleurrijke vormen die je kunt omtoveren tot de leukste figuren. Voor speelvogels vanaf 3 jaar.

Wist je dat je met gewone vormen de leukste en gekste dieren kunt maken als je ze met elkaar combineert?
Prijs: € 14,95
Verschijnt: april 2023 978 90 448 4867 0


Titel: Spelen met vormen Auteur en illustrator: Connie Snoek (Zaltbommel) 273 / Kartonboek 14 pagina’s Formaat: 210 x 220 mm




Prijs: € 15,95 isbn 978 90 448 4402 3

978-9044848670
ISBN
62 Clavis Uitgeverij
Ook van deze illustrator
Speel je mee?
Creatief spelenderwijsenleren
Een boek en een raamstickerset vol kleurrijke letters die omgetoverd worden tot de leukste en gekste dieren. Voor speelvogels vanaf 3 jaar.
Spelen met letters staat vol grappige en originele illustra ties die gemaakt worden met de letters van het alfabet. Met de raamstickers kun je zelf aan de slag om je eigen letterdieren te maken. Veel stickerplezier!

Prijs: € 14,95
Verschijnt: april 2023 isbn 978 90 448 4868 7
Titel: Spelen met letters



Auteur en illustrator: Connie Snoek (Zaltbommel) Vanaf 3 jaar / nur 273 / Kartonboek 14 pagina’s Formaat: 210 x 220 mm ISBN 978-9044848687
Prijs: € 8,95
Verschijnt: april 2023 ean 54 0700998 119 7

Titel: Spelen met letters. Raamstickers

Auteur en illustrator: Connie Snoek (Zaltbommel) Vanaf 3 jaar Formaat: 160 x 210 mm ISBN 978-9044850758

63 Clavis Uitgeverij
Combineer het boek met de raamstickers om zélf ook aan de slag te gaan!
Volg de avonturen van Willow en Warre ook op Ketnet, in Warre en de drie wilgen!


Vrolijke natuureducatie
Ontdek de natuur!
Een leerrijk avontuur voor natuurhelden vanaf 5 jaar.



Prijs: € 18,95
Verschijnt: januari 2023 isbn 978 90 448 5079 6
Warre ligt heerlijk te genieten in zijn tuintje. Tot een enorm kabaal zijn rust verstoort … Samen met het natuurwezentje Willow vlucht hij de natuur in. Daar ontdekt hij niet alleen heel wat dieren en planten, maar leert hij ook dat de natuur het best haar eigen gangetje gaat. ISBN 978-9044850796




Titel: Willow en Warre laten alles lekker wild Serie: Oog voor de natuur Auteur: Yasmine Versteele (Deinze) Illustrator: Bente Pompen (Hasselt) Vanaf 5 jaar / nur 273, 223 Geb. 40 pagina’s Formaat: 210 x 290 mm


65 Clavis Uitgeverij
Luister naar de bomen!
Wat je van bomen leren kunt

Het tweede deel uit de serie ‘Kijk daar, Emma’ over het bos en de bomen, vol weetjes en fan tasierijke illustraties. Voor kinderen vanaf 4 jaar.



Emma en oma wandelen door het bos. Oma vertelt hoe belangrijk de bomen zijn. Wist je bijvoorbeeld dat bomen samenwerken om elkaar te helpen? En dat vogels en insecten smullen van al het lekkers dat ze kunnen vinden in en rond de bomen? Bomen zijn voor dieren zoals supermarkten zijn voor mensen!
Prijs: € 18,95
Verschijnt: april 2023 isbn 978 90 448 4767 3
Titel: Gouden blaadjes en bomen met kronen Auteur: Margreet Schouwenaar (Heiloo) Illustrator: Yuhan Lin (Haelen) Vanaf 4 jaar / nur 273 / Geb. 40 pagina’s Formaat: 250 x 260 mm ISBN 978-9044847673


Ook in deze reeks
Prijs: € 17,95 isbn 978 90 448 4365 1
Clavis Uitgeverij 66
Clavis Margreet Schouwenaar & Wen Sylvestre Margreet Schouwenaar Wen Sylvestre bloemen Klappende rozen boter vol
Over onthaasten
Een vrolijk prentenboek over trager durven gaan in een snelle wereld. Voor miertjes en slakjes vanaf 5 jaar.
Slak is onderweg. Dat gaat heerlijk, zo over het pad. Tot de mieren er dringend langs moeten en er een opstopping ontstaat. Duizendpoot heeft een oplossing: een tweede weg en iedereen moet gewoon wat sneller reizen. Sneller, alsmaar sneller. Maar is dat wel altijd slim?
Prijs: € 17,95
Verschijnt: februari 2023 isbn 978 90 448 4777 2
Titel: Schiet eens op, Slak
Auteur: Bianca Antonissen (Assen)

Illustrator: Katrien Benaets (Halen)



Formaat: 250 x 260 mm ISBN
Vanaf 5 jaar / nur 273 / Geb. 32 pagina’s

67 Clavis Uitgeverij
978-9044847772
De verrassende natuur
Een boek over de wonderlijke camouflagetechnieken van de dieren om ons heen. Voor speurneuzen vanaf 4 jaar.

Is dat een gewone boom, of zit er een krekel op het blad? Is dat een vogel in het riet, of is het gewoon de wind die met de stengels speelt? Sommige dieren kunnen zich heel goed verstoppen. Zo goed zelfs, dat je ze bijna niet ziet … bijna!

Prijs: € 17,95
Verschijnt: februari 2023 isbn 978 90 448 4782 6
Formaat: 250 x 260 mm ISBN 978-9044847826
Titel: Kiekeboe, waar ben ik? Auteur en illustrator: Molly Cranch

Oorspronkelijke titel: Hide and Seek Vertaling: Clavis Uitgeverij Vanaf 4 jaar / nur 273 / Geb. 32 pagina’s

O, zo zit dat!
Een antwoord op kindervragen!
Elke dag gebeuren er dingen waar je meer van wilt weten. In deze serie krijg je duidelijke antwoorden die vaak verrassend zijn. Een infor matief boek over veranderingen op straat. Voor nieuwsgierige kinderen vanaf 5 jaar.





Op straat, in het park en op het stadsplein veran dert er voortdurend wat, maar wanneer gebeurt dat, en vooral: wíé doet dat? Wie repareert de lamp van een kapot verkeerslicht? Wie versiert de kerstboom op het plein? Wie bouwt de kermis, en wie maakt de papiercontainers leeg? In dit boek krijg je antwoorden op vragen die je altijd al hebt willen stellen!
Prijs: € 17,95
Verschijnt: april 2023 isbn 978 90 448 5101 4
Titel: Wie schildert het zebrapad? (op straat)
Serie: Ik zie, ik zie wat jij niet ziet …
Auteur: Marja Baeten (Amsterdam)
Illustrator: Hiky Helmantel (Zeewolde)

Vanaf 5 jaar / nur 210, 223 / Geb. 32 pagina’s
Formaat: 250 x 260 mm
69 Clavis Uitgeverij
978-9044850796 Prijs: € 17,95 isbn 978 90 448 3908 1 Prijs: € 17,95 isbn 978 90 448 4233 3 Prijs: € 17,95 isbn 978 90 448 4271 5 Ook in deze reeks www.clavisbooks.com Marja Baeten & Hiky Helmantel Marja Baeten Hiky Helmantel Wie maakt die vieze trein schoon? Wie maakt die vieze trein schoon? Hoe tankt een vliegtuig? Hoe komt melk in de melktankauto? En hoe komt een auto op een boot? Eerst geven kinderen antwoord op elke vraag. Daarna lees en zie je het echte antwoord. Elke dag gebeuren er dingen om je heen waar je meer van wilt weten. In deze serie zié de antwoorden die normaal verborgen blijven. Voor nieuwsgierige kinderen vanaf jaar. ?? ? Clavis Marja Baeten & Hiky Helmantel Marja Baeten & Hiky Helmantel Waar komt die banaan vandaan? Groente en fruit Waar komt die banaan vandaan? Komen komkommers uit een fabriek? Waarom zitten er pitten in een appel? Word je sterk van broccoli en zijn rozijnen fruit of snoep? Eerst geven kinderen een antwoord. Daarna zie en lees je het echte antwoord. Elke dag gebeuren er dingen waar je meer van wilt weten. In deze serie zie je de antwoorden die normaal verborgen blijven. Voor nieuwsgierige kinderen vanaf jaar. ?? ? Clavis
ISBN
Het ontstaan van de aarde
Terug naar het eerste leven
Een boeiend boek vol schitterende illustraties en leer rijke info, waarin je de geschiedenis van onze planeet vóór de dino’s ontdekt. Voor tijdreizigers vanaf 5 jaar.



Onze aarde bestaat al zo’n 4,5 miljard jaar, en de dino’s leefden zo’n 230 miljoen jaar geleden. Tussen die peri odes zitten nog miljarden jaren. Tijdperken die super interessant zijn, maar nét iets minder bekend. Wist je bijvoorbeeld dat er voor de dino’s ook al leven was op aarde? Dit boek neemt je mee op een ongelooflij ke ontdekkingstocht in de vroegste geschiedenis van onze planeet.
Prijs: € 22,95 Verschijnt: april 2023 isbn 978 90 448 5100 7
Titel: Het leven vóór de dino’s. Het ongelooflijke verhaal van onze aarde Serie: Wow!
Auteur en illustrator: Mack van Gageldonk (Berkel en Rodenrijs) Vanaf 5 jaar / nur 223 / Geb. 72 pagina’s Formaat: 250 x 260 mm
Clavis Uitgeverij 70
ISBN 978-9044851007
Promotie Leerrijke dierenposter
































71 Clavis Uitgeverij
over dino’s Bijna iedereen denkt dat de dinosaurussen uitgestorven zijn. Wat als ik zeg dat ze nog altijd bestaan en zelfs tussen ons leven! Het bewijs? Een authentiek fotoalbum uit de tijd van toen, Clavis DE ONTDEKKING VAN DE DINOSAURUSSEN DE ONTDEKKING VAN DE DINOSAURUSSEN Jan Leyssens & Joachim Sneyers Jan Leyssens & Joachim Sneyers WONDERWAAR www.clavisbooks.com ISBN: 978-9044838916 Begin negentiende eeuw. Mary Anning is pas twaalf jaar oud wanneer ze haar eerste dinosaurusskelet vindt. Niet zomaar een skelet, maar de eerste bijna volledige ichthyosaurus ooit gevonden, terwijl ze eigenlijk gewoon op zoek was naar fossielen om te verkopen. De volgende jaren volgen er nog veel dinosauriërs. En hoewel ze als vrouw niet wordt toegelaten op de universiteit, zou haar onderzoek later mee de basis vormen voor de ontwikkeling van de evolutietheorie, waardoor Mary de geschiedenis inging als een van de belangrijkste paleontologen ooit. Het vierde deel in de serie over wetenschappelijke verwondering. Dromen, durven, denken én doen. Voor onderzoekers vanaf 6 jaar. Mack Mack Dino’s Het raadsel van de reuzen Het raadsel van de reuzen Dino’s Clavis Prijs: € 15,95 isbn 978 90 448 3613 4 Prijs: € 19,95 isbn 978 90 448 3393 5 Prijs: € 10,95 isbn 978 90 448 4811 3 Prijs: € 19,95 isbn 978 90 448 3231 0 Prijs: € 20,95 isbn 978 90 448 4086 5 Prijs: € 20,95 isbn 978 90 448 4031 5 Prijs: € 15,95 isbn 978 90 448 4327 9 Prijs: 20,95 isbn 978 90 448 4087 2 Prijs: € 19,95 isbn 978 90 448 1585 6 Prijs: € 17,95 isbn 978 90 448 3891 6 Kartonboek
Alles







Clavis Uitgeverij 72 rode eekhoorn en de tokeh-gekko. Bijna tot in de wolken! Prijs: € 21,95 Verschijnt: april 2023 isbn 978 90 448 5099 4 Titel: Klimmers Auteur: Reina Ollivier & Karel Claes (Sterrebeek) Illustrator: Steffie Padmos (Eindhoven) Vanaf 5 jaar / nur 223 / Geb. 64 pagina’s Formaat: 235 x 325 mm ISBN 978-9044850994 Promotie: - leerrijke dierenposter
Cadeautip communievoor lentefeestof







Ook dit zijn superbeestjes! 73 Clavis Uitgeverij Prijs: € 21,95 isbn 978 90 448 3678 3 Prijs: isbn 21,95 978 90 448 3878 7 Prijs: € 21,95 isbn 978 90 448 4849 6
Fantasie
Vlieg op de rug van een draak, bezoek een verre planeet, red een onhandige prins uit de toren, of reis naar de toekomst. Alles kan, in je fantasie … en in een boek.

Een grappig verhaal over de stoerste dieren uit het dierenrijk, en een klein muisje. Voor dierenvrienden vanaf 3 jaar.

Wie is de koning van de dieren? De sterke leeuw? De grote olifant? De stoere krokodil, misschien? Fout! De koning van de dieren is de muis, vindt Kleine Muis … En misschien heeft hij wel gelijk!

17,95
Verschijnt: februari 2023 978 90 448 5046 8
Titel: Koning
Auteur: Mark Janssen (Valkenburg aan de Geul) Illustrator: Suzanne Diederen (Valkenburg aan de Geul) Vanaf 3 jaar / nur 273 / Geb. 32 pagina’s Formaat: 250 x 260 mm

75 Clavis Uitgeverij
Prikkelt de fantasie!
De wolkenkoning
Een prachtig prentenboek dat de fantasie prikkelt. Voor kleine dromers vanaf 5 jaar.
Phil is verzot op wolken. Urenlang kan hij op zijn rug in het gras liggen kijken naar de figuren die in de lucht zweven. Als Phil op een dag een wandeling maakt in het bos, ontdekt hij een wolkentrap. En zo klimt hij hele maal tot aan het kasteel van de wolkenkoning met de wondere wolkenborstel.
Prijs: € 17,95
Verschijnt: maart 2023 isbn 978 90 448 4856 4
Titel: Phil in de wolken Auteur en illustrator: Louis-Philippe Vancraeynest (Marke) Vanaf 5 jaar / nur 273 / Geb. 32 pagina’s Formaat: 210 x 290 mm

Clavis Uitgeverij 76
ISBN 978-9044848564
Over verandering en opgroeien
Verandering is spannend
Een verhaal waarin een meisje leert dat ver andering niet betekent dat alles verloren gaat. Voor kinderen en binnenwolkjes vanaf 5 jaar.
Vlak voordat ze voor de eerste keer naar school gaat, leert Benthe een wolkje kennen. Omdat ze allebei niet willen dat hun vriendschap verandert, wordt het wolkje een binnenwolkje. Zo kunnen ze altijd samenblijven. Maar kun je een wolkje wel voor altijd binnenhouden?

Prijs: € 17,95 Verschijnt: mei 2023 isbn 978 90 448 4757 4 Titel: Benthe en het binnenwolkje Auteur en illustrator: Ciara Gavin Oorspronkelijke titel: Beth And Cloud Won’t Change Vertaling: Clavis Uitgeverij Vanaf 5 jaar / nur 273 / Geb. 32 pagina’s Formaat: 210 x 290 mm

77 Clavis Uitgeverij
ISBN 978-9044847574
Een sprookje van Andersen
Prachtige uitgave van een klassiek sprookje
Prachtige uitgave van twee verhalen: het sprookje over het standvastige tinnen soldaatje met één been, en een verrassend verhaal over een van de personages uit het sprookje.
De woonkamer staat vol speelgoed, maar er is één hoek van de kamer die de aandacht trekt van het tinnen sol daatje. Daar staat een danseres op één been te dansen in een papieren huis. Als het speelgoed om middernacht tot leven komt, hebben de soldaat en het meisje alleen oog voor elkaar … Al snel belandt het tinnen soldaatje in een onverwacht avontuur.

20,95
Verschijnt: april 2023 978 90 448 5093 2
Titel: Het tinnen soldaatje Auteur en illustrator: An Leysen (Laakdal) Vanaf 5 jaar / nur 273, 277 / Geb. 56 pagina’s Formaat: 250 x 260 mm


978-9044850932
ISBN
verschenen Prijs:
Eerder
€ 20,95 isbn 978 90 448 5026 0

WafWafWafWafWaf












Clavis Ik ben Pip en dit is mijn boek. Horen jullie dat? Dat is mijn vriend Timotheüs Vanderlange. Timotheüs is de langste hond van de hele wereld. Echt waar. Willen jullie Timotheüs eens zien? Ja? Een grappig en verrassend boek over Pip en zijn grote vriend Timotheüs Vanderlange. Voor kinderen vanaf 3 jaar.
Voorwelterusten-kussersvanaf12maanden, met de wereld rondom het kind als thema. Mack www.clavisbooks.com voor baby’s vanaf 12 m. dagelijks leven vaardigheden emotie de wereld taalontwikkeling vanaf 18 m. vanaf 24 m. Clavis peuter 100 kusjes voor het slapengaan engaan je s MIJN KLEINE wondertje Welkom lieve baby Mack www.clavisbooks.com voor baby’s dagelijks leven vaardigheden taalontwikkeling ISBN 978-9044838411 Mack Kuikentje brengt een bezoekje aan alle babydieren. Van de kleine olifant tot de pasgeboren koala. De babydieren zijn nog heel erg klein. Maar wat zijn ze lief! En wat zijn ze schattig! De mamadieren en papadieren zijn heel trots op hun kleine wondertjes. Eensnoezigboekjewaarineenliefkuikentjeheelveelbabydierenbezoekt. Voornieuwsgierigeaagjesvanaf12maanden, met de emoties van het kind als thema. Mijn kleine wondertje Welkom lieve baby Clavis peuter Kathleen Amant Anna jaar met heel muziek Een BOEK + CD met veel leuke liedjes Clavis Goudlokje Goudlok e Kathleen Amant Kathleen Amant Midden in het bos staat een gezellig berenhuis. Daar wonen drie aardige beren: Papa Beer, Mama Beer en Baby Beer. Op een ochtend wordt de rust in het berenhuis verstoord door een klein meisje dat er heel lief uitziet. Ze heeft goudblonde haren en iedereen noemt haar Goudlokje. Maar is Goudlokje wel zo lief als ze eruitziet? Een warme en originele versie van het klassieke sprookje over Goudlokje en de drie beren. Voor kinderen vanaf 4 jaar. Clavis Vandaag gaan we op pad met de boswachter. Moeten er bomen gekapt of geplant worden? Zijn er dieren in het bos die er eerder niet waren? Is het bos schoon of heeft iemand afval gedumpt? Staat er een wandeling in het donker op het programma? De boswachter houdt het allemaal in de gaten en beschermt de natuur. Een verhelderend informatief boek op kleutermaat over de boswachter en alles wat zij (of hij) doet. Voor natuurvrienden vanaf 4 jaar. Clavis Ron van Maurik Ron van Maurik Ik heb je lief zoals je bent Egel en muis zijn vrienden. Beste vrienden. Als ze spelen, maakt het niet uit wat ze doen, als ze het maar samen doen. Op een dag wil Egel tegen Muis zeggen dat hij zo blij is met hem als vriend. Maar … hij struikelt en landt recht op Muis. Dat prikt! Zou Muis niet blijer zijn met een zachte vriend, in plaats van een met stekels? Een ontroerend verhaal over vriendschap en jezelf kunnen zijn. Voor kinderen vanaf 4 jaar. Prijs: € 13,95 isbn 978 90 448 3156 6 Tweede druk reeds verschenen Prijs: € 29,95 isbn 978 90 448 3938 8 Tweede druk reeds verschenen Prijs: € 17,95 isbn 978 90 448 3656 1 Vijfde druk december 2022 Prijs: € 13,95 isbn 978 90 448 3841 1 Tweede druk reeds verschenen 978 90 448 4331 6 Derde druk reeds verschenen Prijs: € 17,95 isbn 978 90 448 4548 8 Tweede druk december 2022 Prijs: € 17,95 isbn 978 90 448 3941 8 Derde druk reeds verschenen Prijs: € 17,95 ISBN 978 90 448 4786 4 Tweede druk december 2022 Wegens succes herdrukt Clavis Uitgeverij 80

































LEES, VERWONDER en … SCHRIJF! Li Lefébure Op zoek naar inspirerende schrijfopdrachten, zodat je kinderen thuis met plezier kunnen schrijven? Of naar meer creatief zelfvertrouwen voor je leerlingen? Wil je spelen met taal en hun woordenschat ongemerkt vergroten? Kortom meer plezier brengen in lezen én schrijven? Dan is dit het boek dat je zoekt! 81 Clavis Uitgeverij Prijs: € 18,95 isbn 978 90 448 3563 2 Derde druk november 2022 Prijs: € 19,95 isbn 978 90 448 4330 9 Tweede druk november 2022 ISBN 978-9044844252 www.clavisbooks.com Clavis Roel Seidell Roel Seidell Beer is droevig als hij Muis ontmoet. Muis is juist heel blij, want zij heeft een jippiestok. Beer mag die wel even lenen, want van de stok word je vrolijk. Maar de andere dieren in het bos willen natuurlijk ook zo’n magische stok … Komt dat wel goed? Een grappig prentenboek over echte vriendschap, en over blijdschap die je niet zomaar met geld kunt kopen. Voor bromberen en vrolijke muisjes vanaf 5 jaar. Prijs: € 17,95 isbn 978 90 448 4425 2 Tweede druk reeds verschenen Prijs: € isbn 978 90 448 2815 3 Vierde druk november 2022 Bij Anna in de straat Het grote huizenzoekboek Kathleen Amant B ij Anna in de straat Kathleen Amant Bij Anna in de tuin Het grote buitenzoekboek Kathleen Amant Clavis B ij Anna in de tuin Kathleen Amant Anna houdt van buitenspelen. Spelen in de boomhut of de zandbak, springen op de trampoline, fietsen met haar broertje … Soms helpt ze mama en papa ook een handje. Er is zoveel te zien en te doen in de tuin! Eenkleurrijkzoekboekdatkindereninspireert ombuitentespelen.Voornieuwsgierigeaagjes Bij Anna de tuin. Het grote buitenzoekboek ISBN978-9044843309 Het grote beroepenboek Wat zie je bij de kapper? Wat hoort er op de werkplaats? En wat herken je bij de bakker? Sammie en Suzie dromen over later, als ze groot zijn. Wat zullen ze dan worden? Woordjes leren wordt een plezier met dit kartonboek boordevol goed herkenbare plaatjes. Voor nieuwsgierige aagjes vanaf 2,5 jaar. Anita Bijsterbosch Het grote beroepenboek van Sammie en Suzie Trefw.: woordjes leren, kijken Clavis van
Anita Bijsterbosch Het grote beroepenboek van Sammie en Suzie
Sammie en Suzie Anita Bijsterbosch